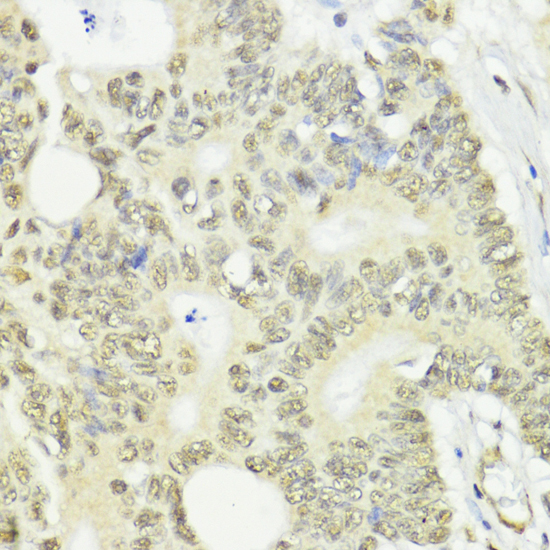
Immunohistochemistry - CTCF Polyclonal Antibody
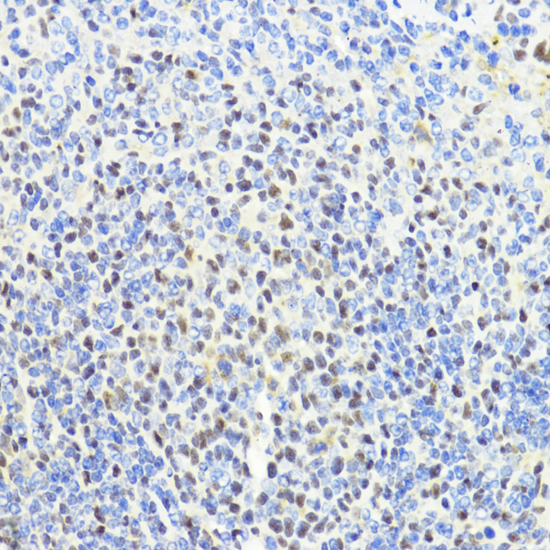
Immunohistochemistry - CTCF Polyclonal Antibody

-
Product Name
CTCF Polyclonal Antibody
- Documents
-
Description
Polyclonal antibody to CTCF
-
Tested applications
WB, IHC, IF, IP, ChIP
-
Species reactivity
Human, Mouse, Rat, Monkey
-
Alternative names
CTCF antibody; MRD21 antibody; CCCTC-binding factor antibody
-
Isotype
Rabbit IgG
-
Preparation
Antigen: Recombinant fusion protein containing a sequence corresponding to amino acids 1-260 of human CTCF (NP_006556.1).
-
Clonality
Polyclonal
-
Formulation
PBS with 0.02% sodium azide, 50% glycerol, pH7.3.
-
Storage instructions
Store at -20℃. Avoid freeze / thaw cycles.
-
Applications
WB 1:500 - 1:2000
IHC 1:50 - 1:200
IF 1:50 - 1:200
IP 1:50 - 1:100
ChIP 1:50 - 1:200 -
Validations

Western blot - CTCF Polyclonal Antibody
Western blot analysis of extracts of various cell lines, using CTCF antibody at 1:1000 dilution.Secondary antibody: HRP Goat Anti-Rabbit IgG (H+L) at 1:10000 dilution.Lysates/proteins: 25ug per lane.Blocking buffer: 3% nonfat dry milk in TBST.Detection: ECL Basic Kit .Exposure time: 5s.

Immunohistochemistry - CTCF Polyclonal Antibody
Immunohistochemistry of paraffin-embedded human colon using CTCF antibody at dilution of 1:100 (40x lens).
Immunohistochemistry - CTCF Polyclonal Antibody
Immunohistochemistry of paraffin-embedded human colon carcinoma using CTCF antibody at dilution of 1:100 (40x lens).

Immunohistochemistry - CTCF Polyclonal Antibody
Immunohistochemistry of paraffin-embedded rat brain using CTCF antibody at dilution of 1:100 (40x lens).

Immunohistochemistry - CTCF Polyclonal Antibody
Immunohistochemistry of paraffin-embedded rat spleen using CTCF antibody at dilution of 1:100 (40x lens).
Immunohistochemistry - CTCF Polyclonal Antibody
Immunohistochemistry of paraffin-embedded mouse spleen using CTCF antibody at dilution of 1:100 (40x lens).

Immunofluorescence - CTCF Polyclonal Antibody
Immunofluorescence analysis of U2OS cells using CTCF antibody at dilution of 1:100. Blue: DAPI for nuclear staining.

Immunoprecipitation - CTCF Polyclonal Antibody
Immunoprecipitation analysis of 200ug extracts of HeLa cells, using 3 ug CTCF antibody . Western blot was performed from the immunoprecipitate using CTCF antibody at a dilition of 1:1000.

Chromatin Immunoprecipitation - CTCF Polyclonal Antibody
Chromatin immunoprecipitation analysis of extracts of HCT116 cells, using CTCF antibody and rabbit IgG. The amount of immunoprecipitated DNA was checked by quantitative PCR. Histogram was constructed by the ratios of the immunoprecipitated DNA to the input.
-
Background
Chromatin binding factor that binds to DNA sequence specific sites. Involved in transcriptional regulation by binding to chromatin insulators and preventing interaction between promoter and nearby enhancers and silencers. Acts as transcriptional repressor binding to promoters of vertebrate MYC gene and BAG1 gene. Also binds to the PLK and PIM1 promoters. Acts as a transcriptional activator of APP. Regulates APOA1/C3/A4/A5 gene cluster and controls MHC class II gene expression. Plays an essential role in oocyte and preimplantation embryo development by activating or repressing transcription. Seems to act as tumor suppressor. Plays a critical role in the epigenetic regulation. Participates in the allele-specific gene expression at the imprinted IGF2/H19 gene locus. On the maternal allele, binding within the H19 imprinting control region (ICR) mediates maternally inherited higher-order chromatin conformation to restrict enhancer access to IGF2. Plays a critical role in gene silencing over considerable distances in the genome. Preferentially interacts with unmethylated DNA, preventing spreading of CpG methylation and maintaining methylation-free zones. Inversely, binding to target sites is prevented by CpG methylation. Plays a important role in chromatin remodeling. Can dimerize when it is bound to different DNA sequences, mediating long-range chromatin looping. Mediates interchromosomal association between IGF2/H19 and WSB1/NF1 and may direct distant DNA segments to a common transcription factory. Causes local loss of histone acetylation and gain of histone methylation in the beta-globin locus, without affecting transcription. When bound to chromatin, it provides an anchor point for nucleosomes positioning. Seems to be essential for homologous X-chromosome pairing. May participate with Tsix in establishing a regulatable epigenetic switch for X chromosome inactivation. May play a role in preventing the propagation of stable methylation at the escape genes from X- inactivation. Involved in sister chromatid cohesion. Associates with both centromeres and chromosomal arms during metaphase and required for cohesin localization to CTCF sites. Regulates asynchronous replication of IGF2/H19. Plays a role in the recruitment of CENPE to the pericentromeric/centromeric regions of the chromosome during mitosis.
Related Products / Services
Please note: All products are "FOR RESEARCH USE ONLY AND ARE NOT INTENDED FOR DIAGNOSTIC OR THERAPEUTIC USE"
